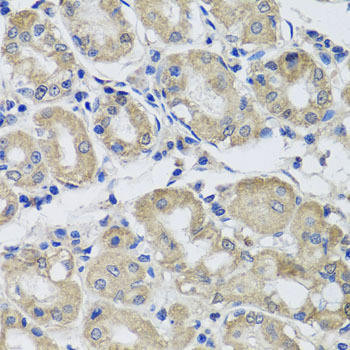
Anti-ST8SIA2 Antibody (CAB7748)

Description
| Antibody Name: | Anti-ST8SIA2 Antibody |
| Antibody SKU: | CAB7748 |
| Antibody Size: | 20uL, 50uL, 100uL |
| Application: | WB IHC |
| Reactivity: | Human, Mouse, Rat |
| Host Species: | Rabbit |
| Immunogen: | Recombinant fusion protein containing a sequence corresponding to amino acids 24-160 of human ST8SIA2 (NP_006002.1). |
| Application: | WB IHC |
| Recommended Dilution: | WB 1:500 - 1:2000 IHC 1:50 - 1:200 |
| Reactivity: | Human, Mouse, Rat |
| Positive Samples: | THP-1, SKOV3, Mouse testis, Mouse brain, Mouse heart, Mouse lung, Rat brain, Rat heart |
| Immunogen: | Recombinant fusion protein containing a sequence corresponding to amino acids 24-160 of human ST8SIA2 (NP_006002.1). |
| Purification Method: | Affinity purification |
| Storage Buffer: | Store at -20'C. Avoid freeze / thaw cycles. Buffer: PBS with 0.02% sodium azide, 50% glycerol, pH7.3. |
| Isotype: | IgG |
| Sequence: | DISE IEEE IGNS GGRG TIRS AVNS LHSK SNRA EVVI NGSS SPAV VDRS NESI KHNI QPAS SKWR HNQT LSLR IRKQ ILKF LDAE KDIS VLKG TLKP GDII HYIF DRDS TMNV SQNL YELL PRTS PLKN KHFG TCAI V |
| Gene ID: | 8128 |
| Uniprot: | Q92186 |
| Cellular Location: | Golgi apparatus membrane, Single-pass type II membrane protein |
| Calculated MW: | 42kDa |
| Observed MW: | 42kDa |
| Synonyms: | ST8SIA2, HsT19690, SIAT8-B, SIAT8B, ST8SIA-II, ST8SiaII, STX, alpha-2 |
| Background: | The protein encoded by this gene is a type II membrane protein that is thought to catalyze the transfer of sialic acid from CMP-sialic acid to N-linked oligosaccharides and glycoproteins. The encoded protein may be found in the Golgi apparatus and may be involved in the production of polysialic acid, a modulator of the adhesive properties of neural cell adhesion molecule (NCAM1). This protein is a member of glycosyltransferase family 29. |
| UniProt Protein Function: | ST8SIA2: May transfer sialic acid through alpha-2,8-linkages to the alpha-2,3-linked and alpha-2,6-linked sialic acid of N-linked oligosaccharides of glycoproteins and may be involved in PSA (polysialic acid) expression. Belongs to the glycosyltransferase 29 family. |
| UniProt Protein Details: | Protein type:EC 2.4.99.-; Glycan Metabolism - glycosphingolipid biosynthesis - ganglio series; Membrane protein, integral; Transferase Chromosomal Location of Human Ortholog: 15q26 Cellular Component: Golgi membrane; recycling endosome; early endosome; integral to Golgi membrane Molecular Function:alpha-N-acetylneuraminate alpha-2,8-sialyltransferase activity; sialic acid binding Biological Process: axon guidance; nervous system development; cellular protein metabolic process; dolichol-linked oligosaccharide biosynthetic process; carbohydrate metabolic process; protein modification process; protein amino acid glycosylation; protein amino acid N-linked glycosylation via asparagine; N-glycan processing; post-translational protein modification; oligosaccharide metabolic process; ganglioside biosynthetic process |
| NCBI Summary: | The protein encoded by this gene is a type II membrane protein that is thought to catalyze the transfer of sialic acid from CMP-sialic acid to N-linked oligosaccharides and glycoproteins. The encoded protein may be found in the Golgi apparatus and may be involved in the production of polysialic acid, a modulator of the adhesive properties of neural cell adhesion molecule (NCAM1). This protein is a member of glycosyltransferase family 29. [provided by RefSeq, Jul 2008] |
| UniProt Code: | Q92186 |
| NCBI GenInfo Identifier: | 2494831 |
| NCBI Gene ID: | 8128 |
| NCBI Accession: | Q92186.1 |
| UniProt Secondary Accession: | Q92186,Q4VAZ0, Q92470, Q92746, |
| UniProt Related Accession: | Q92186 |
| Molecular Weight: | 42,430 Da |
| NCBI Full Name: | Alpha-2,8-sialyltransferase 8B |
| NCBI Synonym Full Names: | ST8 alpha-N-acetyl-neuraminide alpha-2,8-sialyltransferase 2 |
| NCBI Official Symbol: | ST8SIA2 |
| NCBI Official Synonym Symbols: | STX; SIAT8B; HsT19690; ST8SIA-II |
| NCBI Protein Information: | alpha-2,8-sialyltransferase 8B; SIAT8-B; ST8SiaII; sialyltransferase X; sialytransferase St8Sia II; sialyltransferase St8Sia II; alpha-2,8-sialyltransferase 8B 1; sialyltransferase 8 (alpha-2, 8-sialytransferase) B |
| UniProt Protein Name: | Alpha-2,8-sialyltransferase 8B |
| UniProt Synonym Protein Names: | Sialyltransferase 8B; SIAT8-B; Sialyltransferase St8Sia II; ST8SiaII; Sialyltransferase X; STX |
| Protein Family: | Alpha-2,8-sialyltransferase |
| UniProt Gene Name: | ST8SIA2 |
| UniProt Entry Name: | SIA8B_HUMAN |
Additional Information
Product Type: |
Antibody |
Reactivity: |
Human |
Reactivity: |
Mouse |
Reactivity: |
Rat |
Host Species: |
Rabbit |
Isotype: |
IgG |
Antibody Type: |
Polyclonal Antibody |
Research Area: |
Cell Biology |